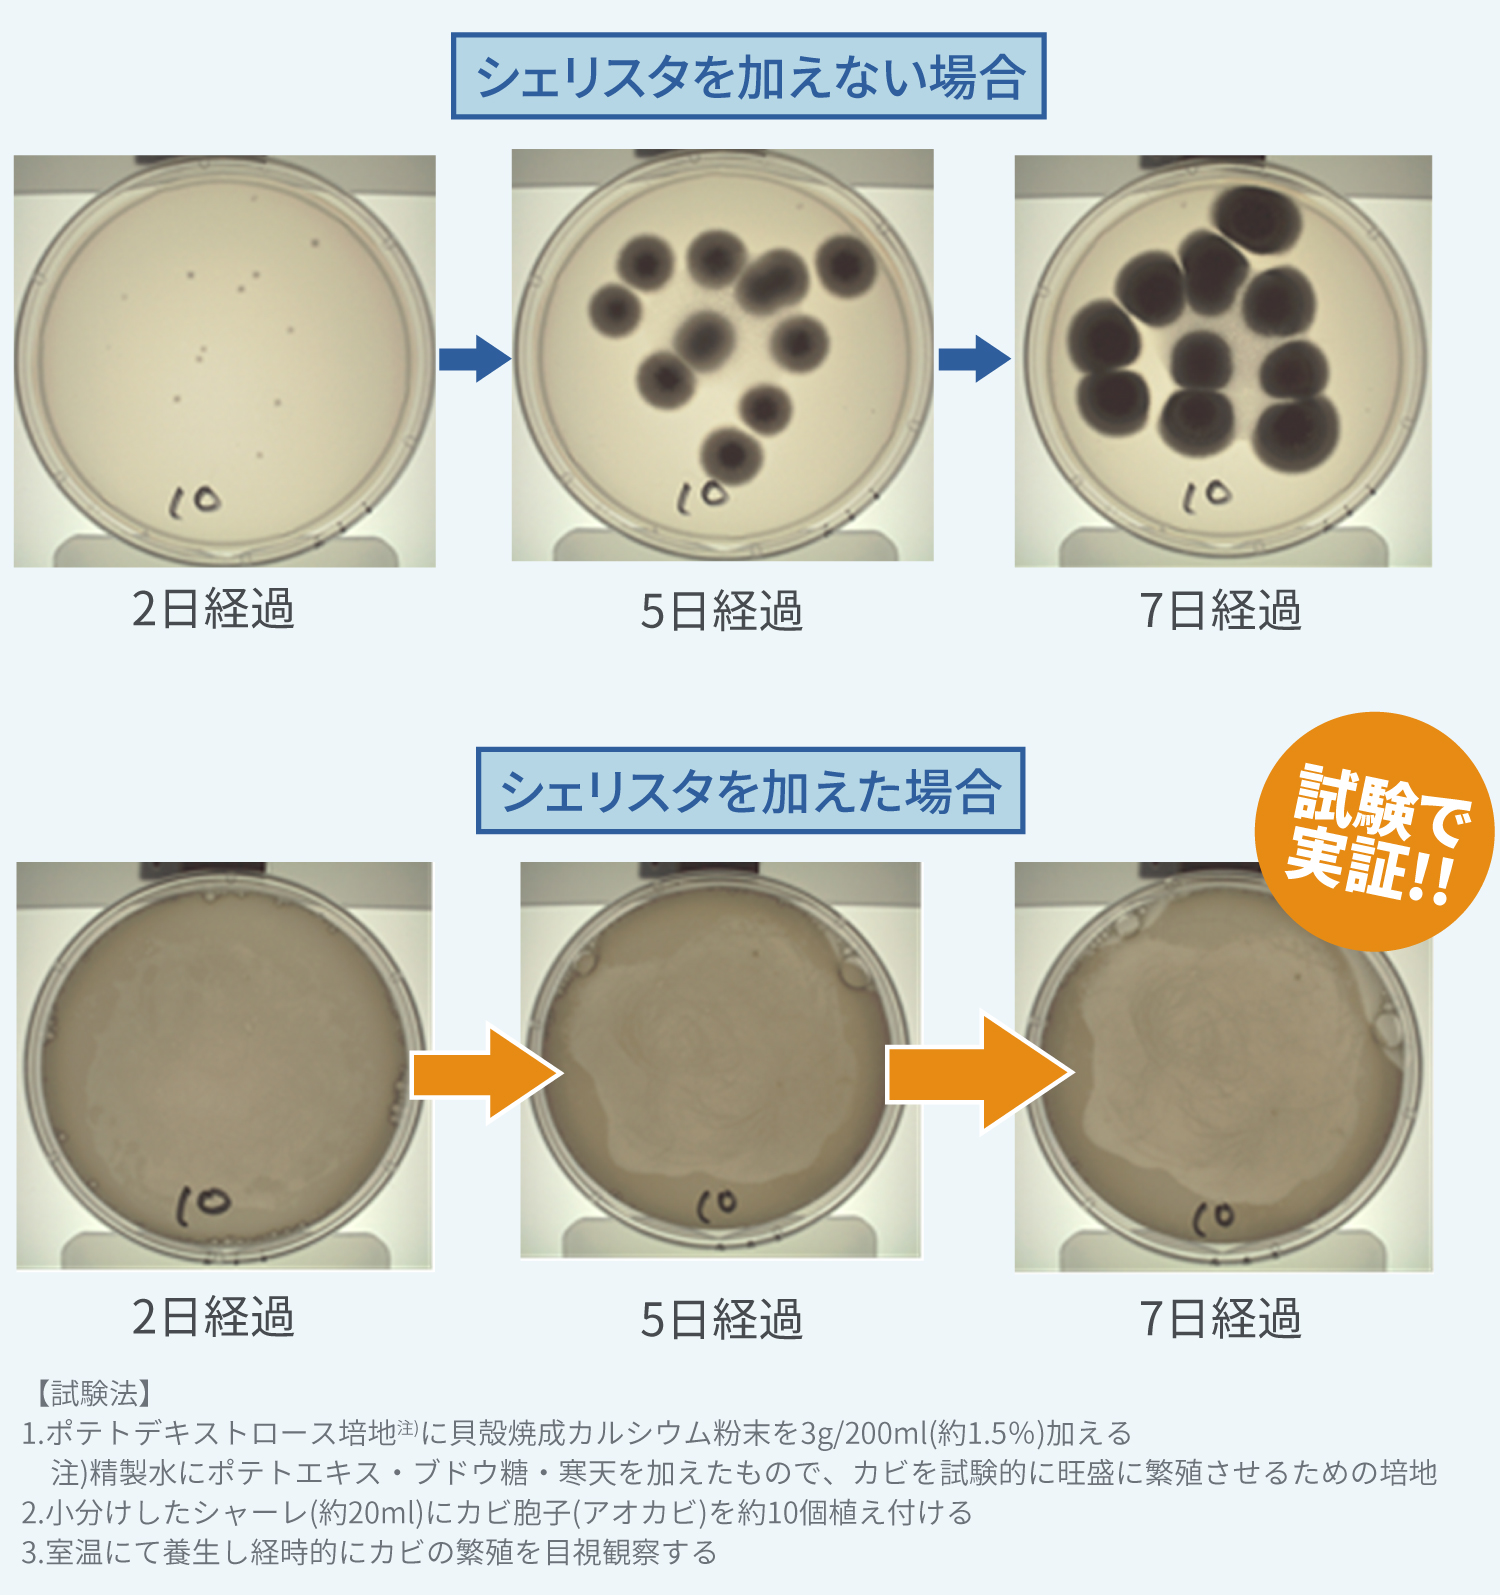
抗カビ試験結果一例

シェリスタ除菌消臭パウダー
除菌洗浄効果と鮮度が長持ちする仕組み

シェリスタのパウダーを水に溶かすと強アルカリ性に変わり、果物や野菜を浸け置くことで、表面に付着した汚れや残留農薬・ワックスなどが剥離・分解されます。さらに雑菌やウイルスも除菌され、効カビ効果も長く持続き、くだものや野菜の鮮度を保つことができるようになります。しかもこの効果を天然成分100%で実現させています。健全な食生活を心がけている方に、シェリスタはまさにうってつけです。
有害物質やワックスが浮いてくる驚きの洗浄効果

実際に野菜や果物をシェリスタに10分間浸け置きしたら浮いてくるのがわかります。これは野菜や果物の表面上に付着した有害物質やワックスなどです。水洗いではなかなか取り除けないまま口にしてしまう可能性もあり、健康上の問題にもなりかねないものです。なぜシェリスタではこれほどまでに有害物質やワックスが除去できるのでしょうか?それはシェリスタの強いアルカリ性の作用だからです。合成界面活性剤は一切使わずに、自然の力だけで除去できるのがシェリスタのポイントです。
強力な除菌能力
シェリスタの強いアルカリ性の力で様々な細菌やウイルスを除菌します。除菌試験をみると、細菌類は10分で99.9%減少、非エンベローブウィルスは78.5%減少しました(検出限界以下)。

赤ちゃんの哺乳瓶や歯固め、子供のマグカップなどまとめて除菌。
シェリスタパウダーで、子供の哺乳瓶や歯固め、マグカップなどをまとめて除菌することができます。代表的な除菌剤のような塩素系の商品とは違い、100%ナチュラル成分で刺激臭もないので、とっても使いやすいです。小さな子供のオモチャなども、綺麗に除菌しますので幅広くお使いください。またシェリスタで浸け置き洗いしていただいて綺麗に除菌すると、その後も坑カビ効果がありますので、梅雨の季節などにも防カビ剤としてご利用いただけます。

高い抗カビ効果
高温多湿の日本では室内や食物に発生するカビも気になるところ。もちろん夏場や梅雨時も発生しますが、冬でも暖房や加湿器の影響でカビが発生しやすい状態になってしまう場合もあります。シェリスタの除菌消臭パウダーはカビ対策でも活躍してくれます。
鮮度が長持ち
シェリスタを使った野菜は、次亜塩素酸ナトリウムが含まれている一般的な除菌消臭剤や水洗いだけの場合に比べて除菌効果が持続します。つまり、野菜や果物の鮮度がより長持ちするということです。このように鮮度を保つ期間が長いので、冷蔵庫にしまう前に野菜やくだものをシェリスタへ漬け置きした後に保存することをおすすめします。

特におすすめの利用シーン
赤ちゃんの哺乳びん

ミルクや唾液が付着している哺乳びんの吸い口などは雑菌が非常に繁殖しやすい環境なので、使用する度に消毒する必要があります。生後間もない赤ちゃんに使うものなので納得できるものを選びたいですね。
赤ちゃんの離乳食

一般的に生後5ヶ月から1年程度で離乳食が始まります。ママのなかには安心・安全な食材で離乳食を作ってあげたいと考えている方も多いと思います。出処のはっきりしているオーガニックな有機野菜などを使うのも大事なことですが、細菌やウイルスを除菌することも大事なことです。
スムージー

健康や美容の目的でスムージーやコールドプレスジュースを飲む方も多いと思います。せっかく作るのであれば、使用する果物や野菜の残留農薬などにも気を付けながら作った方がより満足感を得られます。
サラダ

果物や野菜を生で食べるときは特に残留農薬やワックス、それに細菌やウイルスなどにも注意したいところです。シェリスタは100%天然成分で除菌効果も高いのが特長です。
お風呂

普段のお風呂掃除の前に、浴槽に溜まったお湯にシェリスタを入れ浸け置きすることで、浴槽の汚れを落としカビの繁殖を防ぎます。
洗濯機

洗濯物と洗濯槽の除菌・消臭が一度にできます。洗濯物の部屋干しや生乾きで起こる嫌な臭いを防ぎます。また洗濯槽のカビや黄ばみも予防し、排水口のぬめりや悪臭を取り除きます。また重曹よりアルカリ性が高いため、より強力な除菌効果が期待できます。
よくあるご質問
-
Q すべての有害物質や雑菌を落とせるの?
-
A すべての有害物質や細菌・ウイルスに対して除菌検査等は行ってはおりませんが、様々な菌やウィルスがほとんど検出されなくなった結果が出ています。
-
Q 有害物質や細菌と一緒に野菜や果物の栄養分も落ちるのでは?
-
A いいえ、推奨している浸け置き時間(5~10分程度)では栄養素は落ちません。
-
Q 除去できる汚れや菌は食材の表面上のものだけ?
-
A はい、表面に付着した汚れや雑菌に対して効果があります。
-
Q 浸け置きしたら野菜が変色したけどなぜ?
-
A 食材の種類によっては変色が起こる場合がありますが、品質には問題ありません。(例:ヘタが付いたトマトや皮付きのゴボウは緑色に変わります)
また食材の表面上に付いた汚れや傷がある場合も変色する場合があります。 -
Q 米を浸け置きしたら液体が黄色くなりましたがこれは何ですか?
-
A 溶液が黄色くなるのは酸化した米の油が溶け出したものです。浸ける時間が長すぎると米の食感と色が損なわれてしまいますので、浸け置きの時間は【5秒程度】にしてください。
-
Q 野菜を浸けた後に保存するときのポイントはありますか?
-
A 食材を浸け置きした後、流水で洗い流さずに冷蔵庫で保存すると、カルシウムのコーティングによって抗菌効果がより高まります。乾くと表面が白い粉状のものが付着する場合がありますが、これはカルシウムですので口に入れても問題ございません。気になる場合は洗い流してからお使いください。
使用方法
[野菜・果物の除菌洗浄]
水1リットルに本品を5回程(約1g)振りかけよくかき混ぜます。野菜や果物を5~10分漬けおいたあと流水で十分すすいでください。使用後は溶液をシンクに流し、本製品のフタをしっかり締めてください。
[お米の洗浄]
一度お米を水洗いしたらもう一度水を張り、本品を1~2回振りかけ5秒程かるく研いで水を捨て、あとはいつも通りに研いでください。
[調理器具や食器の除菌]
水1リットルに本品を5回程(約1g)振りかけよくかき混ぜ、調理器具や食器を5~10分浸け置きし、充分にすすいでください。使用後は溶液をシンクに流し、本製品のフタをしっかり締めてください。
[洗濯機の除菌洗浄]
水20リットルに本製品5~10回程(約1~2g)振り入れてください。
[浴槽の除菌洗浄]
水20リットルに本製品5~10回程(約1~2g)振り入れ、5~10分後に浴槽内の水を抜き、充分にすすいでください。
使用上の注意
- 用途以外に使用しないでください。
- 他の除菌剤や洗浄剤と混ぜないでください。
- 本製品は湿気を嫌いますのでフタを必ず閉め、開封後は早めにご使用ください。
- 誤って目や粘膜に付着した場合は水で十分洗い流して、医師の診断を受けてください。
- 誤飲した場合はすぐにうがいをし、2~3杯の水を飲む等の処置をして医師に相談してください。
- 幼児の手の届かない場所に保管してください。
- 食材により変色する場合がありますが品質上の問題はございません。
- 本製品はアルカリ性です。
- 製品の品質向上・改善のため予告なくデザイン・仕様などを変更する場合があります。あらかじめご了承ください。
